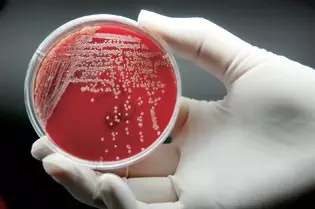
20160624112131 c6edf
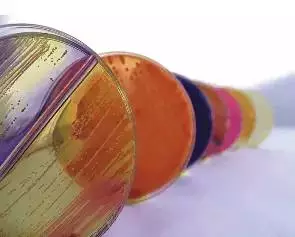
20160624112144 056b1

快速、准确地检测到病原微生物,为临床提供准确及时的药敏试验结果,可以指导临床合理使用抗菌药物,并在医院感染防控中发挥重要作用。但是作为院感专职人员除了会判断多重耐药菌,可能还要知道微生物的生物学特性、抗菌药物的药敏、如何规范采集送检和运送标本及细菌耐药性监测等,才能更好地服务于临床。那么您对微生物报告单了解多少呢?
1、药敏试验
测定抗感染药物在体外对病原微生物有无抑菌或杀菌作用的方法称为药物敏感性试验,简称药敏试验。结果判断标准:目前我国药敏试验判断标准参照CLSI标准文件。

2、药敏结果S、I、R有何代表意义
S是指细菌对抗菌药敏感,使用常规剂量时的平均血浓度超过MIC 5倍以上,用常规剂量通常有效;I是指细菌对抗菌药中度敏感,常规剂量时平均血浓度等于或略高于MIC,需用高剂量或对体内药物浓缩部位的感染可能有效;R是指细菌对某种抗菌药耐药,药物对细菌的MIC 高于应用常规剂量时的血浓度,应用常规剂量治疗通常无效。注意:S、I、R是基于血液中分离的微生物而建立的,也就是说是指血液中微生物的敏感情况,在应用于其它组织器官感染时需考虑PK/PD。
3、药敏试验的药物选择的标准
抗菌药有近几百种,药敏试验中不可能包括每种抗菌药。所测试的抗菌药纸片的种类是根据各类细菌对抗菌药的敏感性及临床可能选用的药物而确定的,同类药物通常只选择1-2个代表品种。CLSI对各种细菌的药敏试验中宜测试的药物品种进行了推荐,并每年更新。实验室结果以标准药敏试验结果为准。

4、了解微生物天然耐药
由于微生物具有区别于其它物种的特殊代谢路径而导致的对某种抗生素耐药,该耐药性具有种属特异性,与抗生素是否接触无关。如肠球菌对除青霉素、氨苄西林以外的所有青霉素类、头孢菌素类抗生素天然耐药,嗜麦芽窄食单胞菌对亚胺培南(泰能)、美罗培南天然耐药、鲍曼不动杆菌对一二代头孢天然耐药等;真菌中曲霉菌对氟康唑天然耐药等。
5、选择报告单上敏感抗生素为什么临床治疗无效?
1). 培养结果是污染菌或定植菌。
2). 体外药敏并不完全等同体内敏感,还要考虑PK/PD。一般来说,敏感≠治疗有效。
3). 细菌本身因素(如诱导耐药、生物膜)等。
应根据感染部位、病情严重程度、药物的抗菌作用及药动学特点选择抗菌药物。
6、培养阳性都需要抗菌药物治疗吗?
1). 培养阳性可能是污染菌或定植菌必须结合临床症状来判断是否为致病菌。
2). 外科感染部位的清创引流与换药,比使用抗菌药更有效。
7、已使用抗生素治疗的患者做微生物检测结果阳性,是否表明现有的抗菌药物无效?
1). 可能是污染或定植菌。
2). 根据微生物药敏试验结果结合临床症状是否减轻或消失再结合抗菌药物疗程来考虑进一步治疗。

8、目前治疗用药前标本送检率不断提高,为什么有意义的培养结果较少?
除了临床和细菌室做好质控,不得不提的是,临床应优化标本送检结构,增加无菌部位标本的送检比例,倡导无菌体液正确采集与培养。
1). 提高血培养的送检率。
2). 尿标本采集前需清洁外阴,留取清洁中段尿,切勿送检导尿袋中的尿液。
3). 外科最好的标本是组织或脓液,而不是拭子。伤口不仅仅抽取脓液,还应采集伤口底部的新鲜肉芽组织等。
4). 怀疑厌氧菌感染时,应采用厌氧转运容器,室温下1h内送达实验室。
5). 脑脊髓液标本不应冷冻,应及时送检等。
9、关注微生物报告单备注信息
1). 分离菌的特定意义和特别处理建议(如:多重耐药菌请注意隔离等)。
2). 与临床及相关部门的联系记录(如:已电告临床与院感科)等。
3). 标本的送检状态。
(内容来源于SIFIC官微,作者:王广芬,转载出于传递更多信息之目的,版权和荣誉归原作者所有。如有侵权请联系我们妥善处理!)


